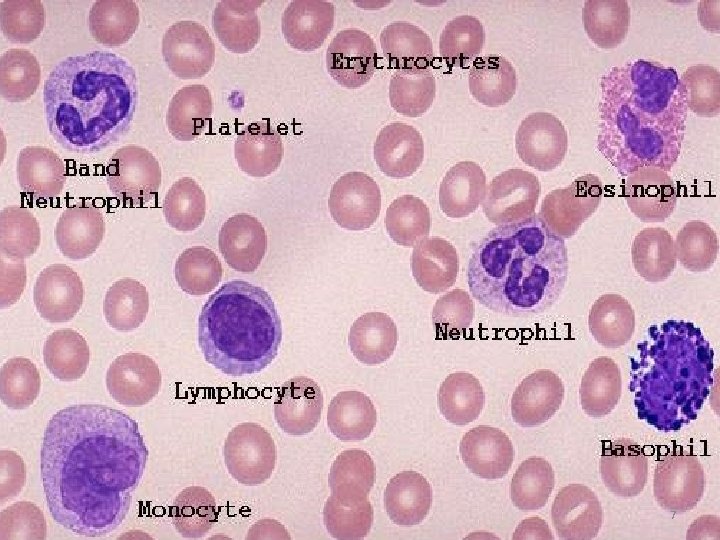
7
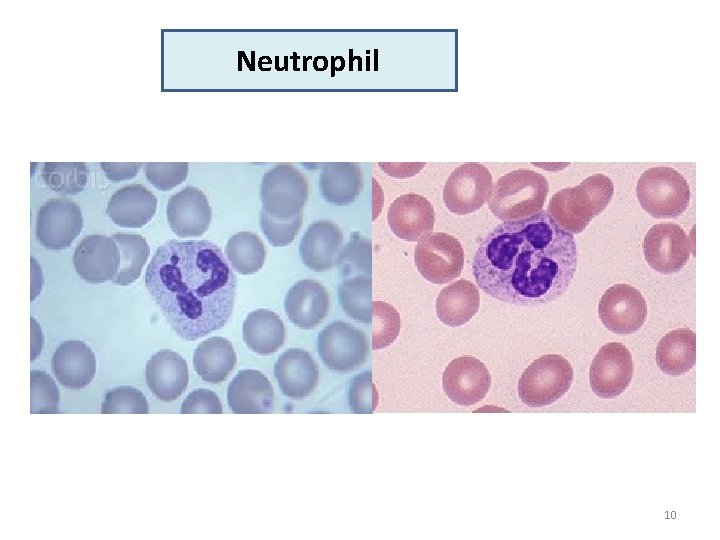
Neutrophil 10
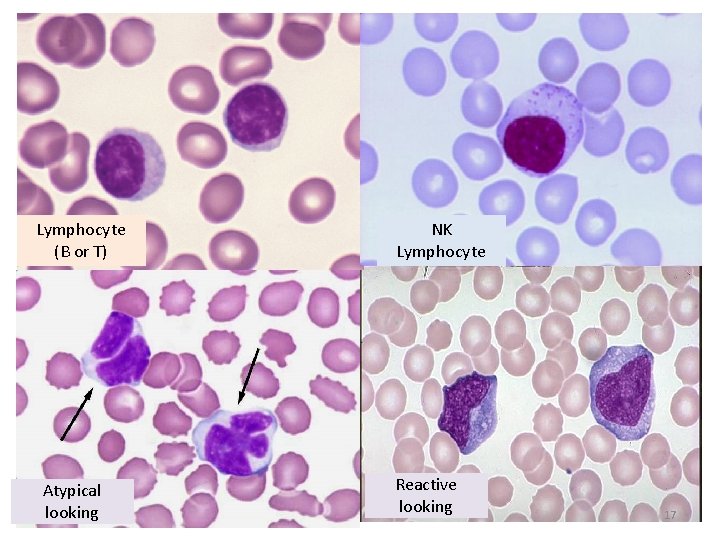
Lymphocyte (B or T) Atypical looking NK Lymphocyte Reactive looking 17

White Blood Cells Dr Mansour Aljabry Assistant Professor

White Blood Cells Dr. Mansour Aljabry Assistant Professor & Consultant Hematologist 1

Hematopoiesis • Hematopoiesis is the process of life long production, multiplication & specialization of blood cells in the bone marrow. • It begins with the most basic blood cell, the stem cell or “pluripotent hematopoietic stem cell” (PHSC). Proliferation Differentiation HSC (mother) 2

Lymphoid Progenitor Hematopoietic stem cell Granulocytic. Monocytic Progenitors Monocytes Myeloid Progenitor Erythroid Progenitor Megakaryocytic –Erythroid Progenitors 3

Hematopoietic growth factors : • Hormones that regulate the proliferation and differentiation of HCS. • Can be administered clinically to stimulate the hematopoiesis : -G-CSF in severe neutropenia -EPO in Sever anemia 4

PAX-5 Lymphoid Progenitor T-bet Hematopoietic stem cell G-CSF SCF FLT 3 -L Granulocytic. Monocytic Progenitors Myeloid Progenitor M-CSF Monocytes EPO Erythroid Progenitor Megakaryocytic –Erythroid Progenitors Thrombopoietin 5

Normal ranges WBC count Cells 4 -11 x 109/L Differential count % Absolute count (x 10 9/L) Neutrophils 50 -70 1. 5 -6. 5 Lymphocyte 20 -44 1. 2 -3. 4 Monocytes 2 -9 0. 1 -0. 6 Bands 0 -6 0 -0. 7 Eosinophils 0 -5 0 -0. 5 Basophils 0 -2 0 -0. 2 6
7

Neutrophil • Phagocytic cell contain a nucleus divided into 2– 5 lobes with pale granulated cytoplasm. • stain a neutral pink (Basophils dark blue while eosinophil is bright red). • They are short lived(≈6 days) and highly motile. 8

Chemotaxis: Migration toward sites of infection or inflammation through detection of IL-8 , TNF γ &C 5 a Neutrophil extracellular traps(NETs): are web-like structures of DNA and fiber that trap and kill microbes extracellularly Superoxide Hydrogen peroxide • Lysozyme • NADPH oxidase • Myeloproxidase (MPO ) 9
Neutrophil 10

Neutrophilia Marginal pool (tissues) Circulating pool (blood) 11

Causes of neutrophilia Benign Neoplastic Bacterial infection (Pyeogenic) Chronic Myeloid leukemia Inflammation and tissue necrosis Polycythemia vera, Essential Thrombocythemia Acute hemorrage or hemolysis Chronic Myelomonocytic Leukemia Steroid therapy (inhibits margination) Non hematological Neoplasms G-CSF treatment Rare inherited disorders Aspleni 12

Leukemoid reaction • Leukocytosis(mainly neutrophilia with left shift) due to physiological response to stress or infection. • Common with : sever or chronic infection , sever hemolysis & metastatic cancers. • Associated with: Toxic granulation , Vaculation & Dohle bodies. 13

Left shift Vaculation Döhle bodies Toxic gran. S. neutrophil 14

Neutropenia • Lower limit of normal is 1. 5 × 10⁹/L • Sever neutropenia : ≤ 0. 5 × 10⁹/L Selective neutropenia Part of general pancytopenia Congenital : - Kostmann syndrome - Benign neutropenia , - Cyclical neutropenia Bone marrow failure Drug induced Chemotherapy Autoimmune (SLE) Acute Leukemia Viral infection (hepatitis , HIV) Lymphoma Some Bacterial infections(Typhoid) Metastatic carcinoma 15

Lymphocytes • Small WBC having spherical nucleus surrounded by a thin layer of non granular cytoplasm. • Fundamental importance in the immune system (Innate &Adaptive) NK cells. B cells 5% 15% T cells 80% 16
Lymphocyte (B or T) Atypical looking NK Lymphocyte Reactive looking 17

Lymphocytosis 1 - Viral infection : • Infectious mononucleosis , cytomegalovirus , rubella, hepatitis, adenoviruses, varicella …. 2 - Some bacterial infection: (Pertussis , brucellosis …) 3 - Other conditions: Allergic drug reactions, splenectomy, dermatitis , hyperthyroidism metastatic carcinoma…. ) 4 - Chronic lymphocytic leukemia (CLL) 5 -Other lymphomas: Mantle cell lymphoma , Hodgkin lymphoma … 18

Lymphocytopenia Selective Lymphocytopenia Part of general pancytopenia Bacterial or fungal sepses Bone marrow failure Post operative state Chemotherapy or radiotherapy Post steroid therapy Acute Leukemia Immunodeficiency (congenital or acquired) Lymphoma Autoimmune disorders (SLE. . ) Metastatic carcinoma 19

Monocytes • Large, phagocytic WBC, having a single well-defined nucleus and very fine granulation in the cytoplasm. • Represents about 2 -9% of WBC • Matures into different types of macrophages at different anatomical locations (skin, spleen, liver …. . ) 20

Monocytes Monocytosis 1 - Chronic infection : (TB , Brucellosis. . ) 2 -Autoimmune : SLE. . Monocytopenia Selective monocytopenia : Hairy cell leukemia 3 -Chronic neutropenia 4 -Acute leukemia (AML M 5) 5 -Chronic Myelomonocytic leukemia 21

Eosinophil • Granular leukocyte having a nucleus with two lobes and cytoplasm containing bright red coarse and round granules. • Major functions : 1 -Antiparasitic and bactericidal activity, 2 -Participating in immediate allergic reactions, 3 -Modulating inflammatory responses. 22

Eosinophilia Causes: C H I N A Connective tissue diseases Helminthic parasitic infections Idiopathic: Hypereosinophilic syndrome Neoplasia: eosinophilic leukaemia, lymphoma or MPN Allergy 23 23

Basophil • Phagocytic leukocyte of characterized by numerous coarse bluish-black granules of variable size. • Mature to tissue mast cells. • Functions of Basophils - Major role in immediate allergic reaction (Ig. E) - Anticoagulant activity (Heparin) - Vasodilatation (Histamine) 24

Basophilia 1 -Neoplasia (CML, mastocytosis, basophilic leukaemia, MPN) 2 -Hypothyroidism 3 -Some viral infections (Chickenpox) 4 -Inflammatory conditions 5 -Drugs (IL 3, oestrogen) 6 -Hyperlipidaemia 25 25

leukoerythroblastic picture Bone marrow response in which nucleated red blood cells and immature leukocytes are released in the blood Causes: • Metastatic neoplasm • Primary Myelofibrosis • Severe hemolysis (Thalassemia major) • Severe infection ( Miliary TB) 26

- Slides: 27